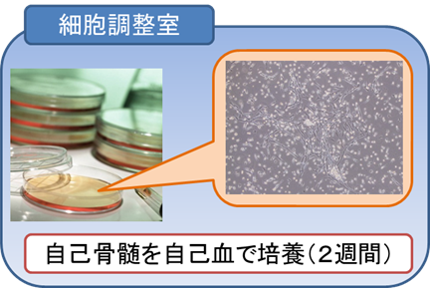
zu2.png

トップページ > 診療科・部門 > 診療科(外科系) > 心臓血管外科 > 末梢動脈疾患に対する血管新生治療
末梢動脈疾患に対する血管新生治療
国立国際医療研究センターでは、「自己骨髄由来培養間葉系細胞移植による末梢動脈疾患に対する血管新生治療」研究を実施することになりました。
最近、生活習慣様式の欧米化に伴って、動脈硬化の影響で、手足の先に血液が行き渡らなくなる、末梢動脈疾患(閉塞性動脈疾患)が、増加しています。
それに伴い、手足を切断せざるをえない患者さんが多くいると言われています。
自己骨髄由来培養間葉系細胞移植ってどんな治療?
細胞移植といっても、患者さん自身の骨髄細胞を使用するために、拒絶反応などの起こる可能性はありません。この方法は、患者さんの虚血に陥った四肢の筋肉内に細胞(間葉系細胞)を40~60ケ所注射するもので、骨髄細胞の一部は筋肉内で血管へと分化(変化)します。また移植した細胞がいろいろな因子を産生して、新しい血管を作ることを促進すると考えられています。
![]() |
![]() |
![]() |
|||
![]() |
血流改善の度合いを評価![]() |
期待できること
新しく血管を作り、患肢の血流を改善することです。それに伴って歩行時や安静時の痛みがなくなったり、足の潰瘍が治る可能性が期待できます。
また、将来の患肢切断を回避あるいは先延ばしできる可能性もあります。
実際の移植はどのように進むの?
末梢動脈疾患(閉塞性動脈硬化症、バージャー病)の患者さんに対し、自身の骨髄から局所麻酔を用い取り出した少量の骨髄を、自身の血液から作った多血小板血漿を用い培養し、増やした間葉系細胞を移植することにより新しい血管を作りだす治療の研究を行います。
どのような人が対象になるの?
末梢動脈疾患(閉塞性動脈硬化症・バージャー病)の方
受けるにはどうすればいいの?
自己骨髄由来培養間葉系細胞移植を希望される方、より詳しく知りたい方は、かかりつけの医師を通してご相談いただくか、私たちに直接ご相談ください。
連絡先
自己骨髄由来培養間葉系細胞移植による末梢動脈疾患に対する血管新生治療

福田 尚司(ふくだ しょうじ)主任研究者
センター病院 心臓血管外科
電話番号: 03-3202-7181(代表) 内線5393
メールアドレス:sfukuda@hosp.ncgm.go.jp
専門の医師により血管新生の詳しい説明を致します。移植を受けたいご希望がある方には、適応があるか検査を行います。移植の適応があると判断されましたら、治療の準備となります。